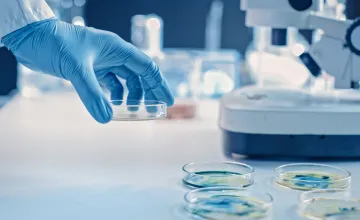
Scientist holding a petri dish in a laboratory

Technology transfer is the process that universities and other research organizations use to translate research discoveries and scientific findings into new products, technologies, drugs and other services that benefit the public. AAU promotes activities to improve university technology transfer through providing a forum through which its members share information about institutional policies and best practices they use to move ideas from the laboratory to the marketplace. AAU also advocates for maintaining and strengthening federal technology transfer policies, including the Bayh-Dole Act of 1980 which fundamentally changed the nation’s system of technology transfer by enabling universities to retain title to inventions and take the lead in patenting and licensing groundbreaking discoveries.

Search Our Key Issue Library
Browse recent items or search for a specific topic or document.